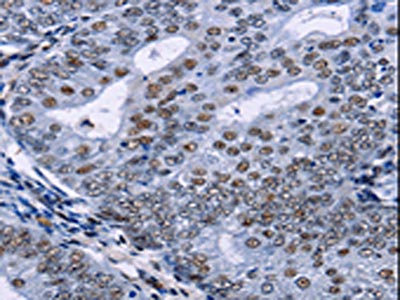

CREBBP Antibody
-
中文名稱:CREBBP兔多克隆抗體
-
貨號:CSB-PA824713
-
規(guī)格:¥1100
-
圖片:
-
The image on the left is immunohistochemistry of paraffin-embedded Human cervical cancer tissue using CSB-PA824713(CREBBP Antibody) at dilution 1/5, on the right is treated with synthetic peptide. (Original magnification: ×200)
-
The image on the left is immunohistochemistry of paraffin-embedded Human esophagus cancer tissue using CSB-PA824713(CREBBP Antibody) at dilution 1/5, on the right is treated with synthetic peptide. (Original magnification: ×200)
-
-
其他:
產(chǎn)品詳情
-
Uniprot No.:
-
基因名:
-
別名:CBP antibody; CBP_HUMAN antibody; CREB binding protein antibody; CREB-binding protein antibody; Crebbp antibody; Cyclic AMP responsive enhancer binding protein antibody; KAT3A antibody; RSTS antibody; RTS antibody; Rubinstein Taybi syndrome antibody
-
宿主:Rabbit
-
反應(yīng)種屬:Human,Mouse,Rat
-
免疫原:Synthetic peptide of Human CREBBP
-
免疫原種屬:Homo sapiens (Human)
-
標(biāo)記方式:Non-conjugated
-
抗體亞型:IgG
-
純化方式:Antigen affinity purification
-
濃度:It differs from different batches. Please contact us to confirm it.
-
保存緩沖液:-20°C, pH7.4 PBS, 0.05% NaN3, 40% Glycerol
-
產(chǎn)品提供形式:Liquid
-
應(yīng)用范圍:ELISA,IHC
-
推薦稀釋比:
Application Recommended Dilution ELISA 1:500-1:5000 IHC 1:5-1:20 -
Protocols:
-
儲存條件:Upon receipt, store at -20°C or -80°C. Avoid repeated freeze.
-
貨期:Basically, we can dispatch the products out in 1-3 working days after receiving your orders. Delivery time maybe differs from different purchasing way or location, please kindly consult your local distributors for specific delivery time.
-
用途:For Research Use Only. Not for use in diagnostic or therapeutic procedures.
相關(guān)產(chǎn)品
靶點詳情
-
功能:Acetylates histones, giving a specific tag for transcriptional activation. Also acetylates non-histone proteins, like DDX21, FBL, IRF2, MAFG, NCOA3, POLR1E/PAF53 and FOXO1. Binds specifically to phosphorylated CREB and enhances its transcriptional activity toward cAMP-responsive genes. Acts as a coactivator of ALX1. Acts as a circadian transcriptional coactivator which enhances the activity of the circadian transcriptional activators: NPAS2-ARNTL/BMAL1 and CLOCK-ARNTL/BMAL1 heterodimers. Acetylates PCNA; acetylation promotes removal of chromatin-bound PCNA and its degradation during nucleotide excision repair (NER). Acetylates POLR1E/PAF53, leading to decreased association of RNA polymerase I with the rDNA promoter region and coding region. Acetylates DDX21, thereby inhibiting DDX21 helicase activity. Acetylates FBL, preventing methylation of 'Gln-105' of histone H2A (H2AQ104me). Functions as a transcriptional coactivator for SMAD4 in the TGF-beta signaling pathway.
-
基因功能參考文獻(xiàn):
- Co-immunoprecipitation analysis and siRNA-mediated suppression of CREB expression indicated that phospho-CREB has a positive effect on pro-inflammatory gene expression in the crosstalk between BAFF- and TLR4-mediated signaling by forming trimeric complexes containing NF-kappaB, CBP, and CREB PMID: 28374824
- CREBBP and p300 may contribute to genome stability by fine-tuning the functions of DNA damage signaling and DNA repair factors, thereby expanding their role as tumor suppressors. (Review) PMID: 29170789
- This review is focused on the different targets and functions of p300/CBP in physiological and pathological processes, including lipogenesis, lipid export, gluconeogenesis, and liver fibrosis, also provided some nutrients as the regulator of p300/CBP for nutritional therapeutic approaches to treat liver diseases. PMID: 29862292
- provide evidence that both CREBBP and EP300 are bona fide tumor suppressors that control MHCII expression and promote tumor immune control; mutational inactivation of CREBBP, but not of EP300, has additional cell-intrinsic engraftment and growth-promoting effects PMID: 28831000
- BRD, PHD, and ZZ domains interact with SUMO-1 and Ubc9, and function as an intramolecular E3 ligase for SUMOylation of the cell cycle regulatory domain 1; the BRD is essential for histone H3 acetylation PMID: 28630323
- CREBBP Mutation is associated with Rubinstein-Taybi Syndrome and Medulloblastoma. PMID: 29551561
- The recruitment of COASY inhibits CBP-mediated TPX2 acetylation, promoting TPX2 degradation for mitotic exit. PMID: 29531224
- GATA3 interacts with and is acetylated by the acetyltransferase CBP. The major acetylated site of GATA3 in lung adenocarcinoma cells is lysine 119. PMID: 29453984
- Our study demonstrated the association of low CREBBP expression with adverse clinical and biological features, poor prednisone response, high MRD levels and inferior outcomes in paediatric Chinese patients with ALL who were treated with the BCH- 2003 and CCLG- 2008 pro- tocols. PMID: 28452416
- Knockdown of CREB suppressed the expression of matrix metallopeptidase (MMP)2/9. PMID: 28487942
- mutation unlikely to be an early event in squamous cell carcinogenesis PMID: 27094574
- Ectopic expression of EP300-ZNF384 and CREBBP-ZNF384 fusion altered differentiation of mouse hematopoietic stem and progenitor cells and also potentiated oncogenic transformation in vitro.our results indicate that gene fusion is a common class of genomic abnormalities in childhood ALL and that recurrent translocations involving EP300 and CREBBP may cause epigenetic deregulation with potential for therapeutic targeting. PMID: 27903646
- The CREBBP acetyltransferase is a haploinsufficient tumor suppressor in B-cell lymphoma. PMID: 28069569
- Understanding the effects of disrupting the acetyltransferase activity of CBP/p300 could pave the way for new therapeutic approaches to treat patients with these diseases PMID: 27380996
- How cancer cells use p300/CBP in their favor varies depending on the cellular context and is evident by the growing list of loss- and gain-of-function genetic alterations in p300 and CBP in solid tumors and hematological malignancies.[review] PMID: 27881443
- Mutations of CREBBP and SOCS1 are independent prognostic factors in diffuse large B cell lymphoma; CREBBP and EP300 mutations remained significant to predict worse OS, PFS, and EFS. PMID: 28302137
- We conclude that patients with missense mutations in this specific CREBBP region show a phenotype that differs substantially from that in patients with Rubinstein-Taybi syndrome, and may prove to constitute one (or more) separate entities. PMID: 27311832
- Pre-eclampsia occurs in 12/52 mothers of EP300 mutated individuals versus in 2/59 mothers of CREBBP mutated individuals, making pregnancy with an EP300 mutated fetus the strongest known predictor for pre-eclampsia PMID: 27648933
- Earlier loss of Crebbp is advantageous for lymphoid transformation and inform the cellular origins and subsequent evolution of lymphoid malignancies. PMID: 28825697
- Data show that specifically inhibiting the interaction between CBP and catenin with ICG-001 results in the differentiation of quiescent drug-resistant chronic myelogenous leukemia-initiating cells (CML LICs). PMID: 26657156
- 5-FU promotes global histone de-acetylation by enhancing the degradation of p300/CBP in colorectal neoplasms. PMID: 28465257
- CREBBP mutations were associated with inferior progression-free survival (PFS), whereas mutations in previously unreported HVCN1, a voltage-gated proton channel-encoding gene and B-cell receptor signaling modulator, were associated with improved PFS. PMID: 28064239
- the rate-limiting transition state for binding between the TAZ1 domain of CREB binding protein and the intrinsically disordered transactivation domain of STAT2 (TAD-STAT2) by site-directed mutagenesis and kinetic experiments (Phi-value analysis) and found that the native protein-protein binding interface is not formed at the transition state for binding. PMID: 28707474
- In targeted sequencing, a disruptive mutation of TNFAIP3 was the most common alteration (54%), followed by mutations of TBL1XR1 (18%) and cAMP response element binding proteins (CREBBP) (17%). PMID: 28152507
- A mosaic variant in CREBBP identified as pathogenic in a patient with overlapping clinical features of Rubinstein-Taybi and Filippi syndromes tested negative for CKAP2L. PMID: 26956253
- CREBBP-BCORL1 fusion is associated with ossifying fibromyxoid tumors. PMID: 27537276
- Mapping the interactions of adenoviral E1A proteins with the p160 nuclear receptor coactivator binding domain of CBP PMID: 27699893
- CREBBP mutations might assist in enhancing oncogenic RAS signaling in acute lymphoblastic leukemia but do not alter response to MEK inhibitors. PMID: 27979926
- Mutations identified in patients with and without classical Rubinstein-Taybi syndrome lead to skipping of exon20 of CREBBP. PMID: 27165009
- Letter/Case Report: duplication mutation, c.5837dupC (p.P1947TfsX19), in CREBBP in patient with Rubinstein-Taybi syndrome with multiple pilomatricomas. PMID: 27342041
- C646 treatment attenuated ETV1 protein expression and inactivated KIT-dependent pathways. Taken together, the present study suggests that CBP/p300 may serve as novel antineoplastic targets and that use of the selective HAT inhibitor C646 is a promising antitumor strategy for Gastrointestinal stromal tumors. PMID: 27633918
- The CREBBP gene is believed to be the dosage-sensitive critical gene responsible for the reciprocal duplication and deletion syndrome PMID: 26873618
- Results show that CREBBP was the most frequent target of epigenetic modification in juvenile myelomonocytic leukemia. PMID: 27158276
- Data show that mutation of key residues in the binding site abolishes binding and that small ubiquitin-like modifier 1 (SUMO1) can simultaneously and non-cooperatively bind both the ZZ domain and a canonical SIM motif of CREB-binding protein (CBP/p300). PMID: 27129204
- Cyclic AMP Response Element Binding Protein Mediates Pathological Retinal Neovascularization via Modulating DLL4-NOTCH1 Signaling PMID: 26870802
- high expression of both CREB-binding protein and cleavage and polyadenylation specific factor 4 predicted a poor prognosis in the patients with lung adenocarcinomas. PMID: 26628108
- RFPL3 and CBP have roles in upregulating hTERT activity and promoting lung cancer growth PMID: 26318425
- Disruption of beta-catenin/CBP signaling inhibits human airway epithelial-mesenchymal transition and repair. PMID: 26315281
- Intrinsic protein disorder plays a prominent role in the function and interactions of the transcriptional co-activators CBP and p300. (Review) PMID: 26851278
- 42 new CREBBP mutations were reported in 46 Rubinstein-Taybi syndrome patients. PMID: 25388907
- Computational simulations were used to understand how phosphorylation affects the structure of the p53 terminal transactivation domain in complex with the CBP TAZ2 domain. PMID: 26742101
- these data suggest that CBP/p300 are promising therapeutic targets across multiple subtypes in acute myeloid leukemia. PMID: 25893291
- Conclude that the CBP/beta-catenin complex is a core component of the MDR1 transcriptional "enhancesome" in neoplasms. PMID: 25968898
- WNT/beta-catenin signaling does not affect nuclear translocation of the RelA subunit of NF-kappaB or its association with CBP (also known as CREBBP) PMID: 26021349
- Kaposi's sarcoma-associated herpesvirus vIRF4 targets the beta-catenin/CBP cofactor and blocks its occupancy on the cyclin D1 promoter, suppressing the G1-S cell cycle progression and enhancing virus replication. PMID: 26491150
- Case Report: novel nonsense mutation of CREBBP in a patient with Rubinstein-Taybi syndrome. PMID: 26603346
- destabilization of p300/CBP by downregulation of iASPP expression levels appears to represent a molecular mechanism that contributes to chemoresistance in melanoma cells. PMID: 25675294
- these findings suggest that sumoylation plays a critical role in the spatiotemporal co-activation of CLOCK-BMAL1 by CBP for immediate-early Per induction and the resetting of the circadian clock. PMID: 26164627
- First study of Korean Rubinstein-Taybi syndrome patients indicating distinct geographic distribution of CREBBP mutations PMID: 25108505
- CREBBP mutations are associated with recurrence in hyperdiploid acute lymphoblastic leukemia. PMID: 25917266
顯示更多
收起更多
-
相關(guān)疾病:Rubinstein-Taybi syndrome 1 (RSTS1)
-
亞細(xì)胞定位:Cytoplasm. Nucleus. Note=Recruited to nuclear bodies by SS18L1/CREST. In the presence of ALX1 relocalizes from the cytoplasm to the nucleus.
-
數(shù)據(jù)庫鏈接:
Most popular with customers
-
-
YWHAB Recombinant Monoclonal Antibody
Applications: ELISA, WB, IHC, IF, FC
Species Reactivity: Human, Mouse, Rat
-
Phospho-YAP1 (S127) Recombinant Monoclonal Antibody
Applications: ELISA, WB, IHC
Species Reactivity: Human
-
-
-
-
-